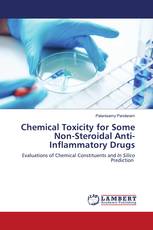
Chemical Toxicity for Some Non-Steroidal Anti-Inflammatory Drugs

Prevalence and correlates of Trachoma infection among children 1-9 years
Facilities factors associated to prevalence of Trachoma among children (1-9 years) in Kapenguria Sub- county
Moses Machar - ISBN: 978-620-3-02589-7
КУЛЬТУРНО-ПСИХОЛОГИЧЕСКИЕ ТРАКТОВКИ ОБРАЗА ЖЕНСКОГО ВОДНОГО ДУХА
Юлия Фокина - ISBN: 978-620-2-92421-4
Искусственный пористый заполнитель для легких бетонов
Технология получения и свойства
Андрей Косарев - ISBN: 978-620-2-92301-9
Effect of Carcinogenic Polycyclic Aromatic Hydrocarbons on Environment
Proceedings of one day National Symposium
Meet Kamal, Archana Pandey - ISBN: 978-620-3-02487-6
The Concept of the Elite in Sociology
Theoretical Approaches to Social Inequalities
Smiljana Mirkov, Marija Runić Ristić - ISBN: 978-620-3-02533-0
Пути Улучшения Финансовых Результатов Деятельности Предприятия
Монография
Гульнара Альбертовна Гареева, Диана Рамилевна Григорьева - ISBN: 978-620-2-92374-3
Transmitting Languages Transmitting cultures
Learning Languages means Learning Cultures
Nasiba Iskanova, Saodat Khasanova - ISBN: 978-620-3-02520-0
Modelling and Performance Analysis
of Cascaded Two-Level Inverter Based Grid Connected and Stand-Alone Photovoltaic Systems
Nayan Kumar, Tapas Kumar Saha, Jayati Dey - ISBN: 978-620-2-51536-8
Pedagogy of Social Science Teaching
A Complete Book on the Teaching of Social Science for B.Ed. & D.El.Ed. students of Indian Universities
Dr. Rajesh Ekka - ISBN: 978-620-2-92154-1
Chemical Toxicity for Some Non-Steroidal Anti-Inflammatory Drugs
Evaluations of Chemical Constituents and In Silico Prediction
Palanisamy Pandaram - ISBN: 978-620-2-92153-4